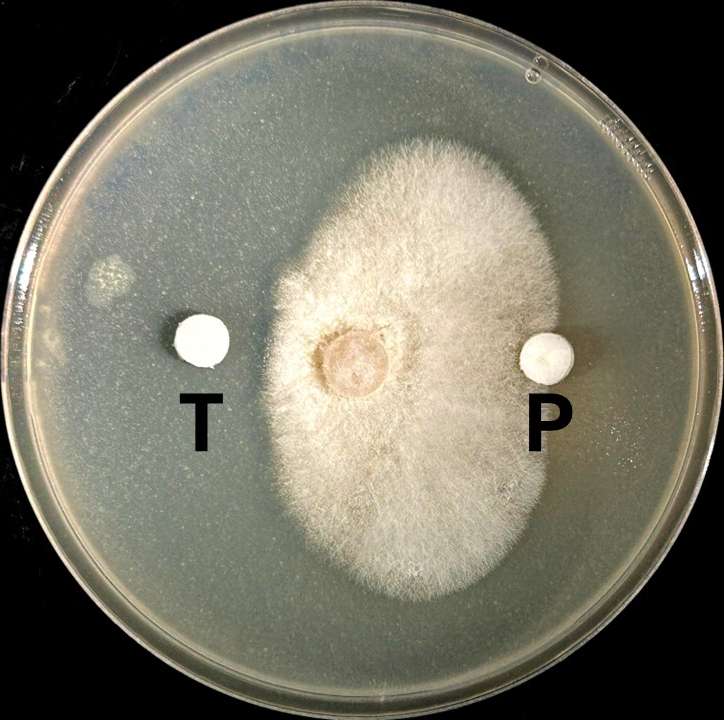
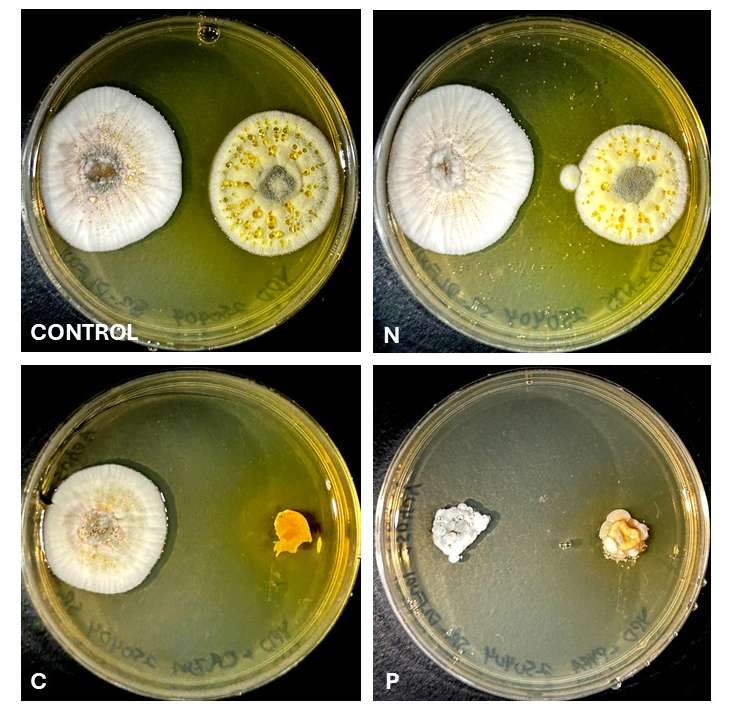

When fungi aren’t fun – Testing antifungal susceptibility
Fungal Contamination: The Challenge
While fungi make significant contributions in many industries, their presence isn’t always welcome—particularly in propagation or micropropagation of plants in greenhouses or laboratories. When fungal contamination or disease occurs, selecting an appropriate antifungal compound is the next step. With so many antifungals available, and differences in susceptibility between strains and organisms, identifying an effective antifungal treatment can be a complicated process.
This challenge is illustrated by several novel plant pathogens Proxima recently isolated and identified. To help our client eliminate this pathogen, we deployed two strategies for antifungal susceptibility testing.
The Traditional Disk Method for Susceptibility Testing
This method is commonly employed in medical microbiology laboratories to determine the efficacy of antibiotics and antifungals against human and animal infections, but it also has applications in agricultural settings. A sterile paper disk is soaked in a known amount of antifungal compound and placed on an agar plate a defined distance from an inoculation of the test organism.
As shown in Figure 1, compound T was successful in preventing growth, whereas the organism was unaffected by compound P.
While this method is useful for testing sensitivity to multiple antifungals at one time, it does have drawbacks. These include ambiguity due to different diffusion rates of the compounds through the media, potential synergistic effects, and the need to adjust the quantity of compound applied to ensure the zone of exclusion is neither too large nor too small. It is useful where one organism is to be tested against numerous antifungals, but limited in throughput when testing of multiple organisms is desired.
Testing with Antifungal Compounds Added to the Medium
The second method, illustrated in Figure 2, involves plating fungal isolates on nutrient-rich agar with a known concentration of a single antifungal added to the medium in each plate.
As shown in Figure 2, both isolates are sensitive to compound P, neither are sensitive to compound N, and only one is sensitive to compound C. This method has some disadvantages—if two organisms have different growth rates, a fast-growing organism may obscure the growth, or lack thereof, of the other isolate on the plate. It also doesn’t provide relative susceptibility data, though this is often unimportant for practical applications in agricultural science since antifungals are usually applied at concentrations well above the minimum inhibitory concentration.
This strategy is particularly useful when testing susceptibility of two or more organisms, as it allows for easy cross-comparison of the effects on each isolate.
Choosing the Right Method for Antifungal Susceptibility Testing
Whether using the disk diffusion or plate method for fungal susceptibility testing, these strategies provide valuable information and save time and money when eliminating fungal pathogens from plants in the field or laboratory.

